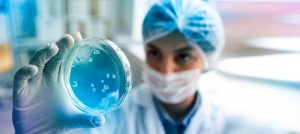
Pioneering Productivity: How a Biopharmaceutical Leader Revolutionized Collaboration with Microsoft Solutions

Microsoft Solutions
6 min
Microsoft Solutions
6 min
The AI Engineering Paradox: Why We’re Coding Faster but Shipping Slower (And How to Fix It)
By Mandar Zope, AI Practice Lead, Cambay Solutions It’s the defining conundrum of the 2026 engineering landscape. We…